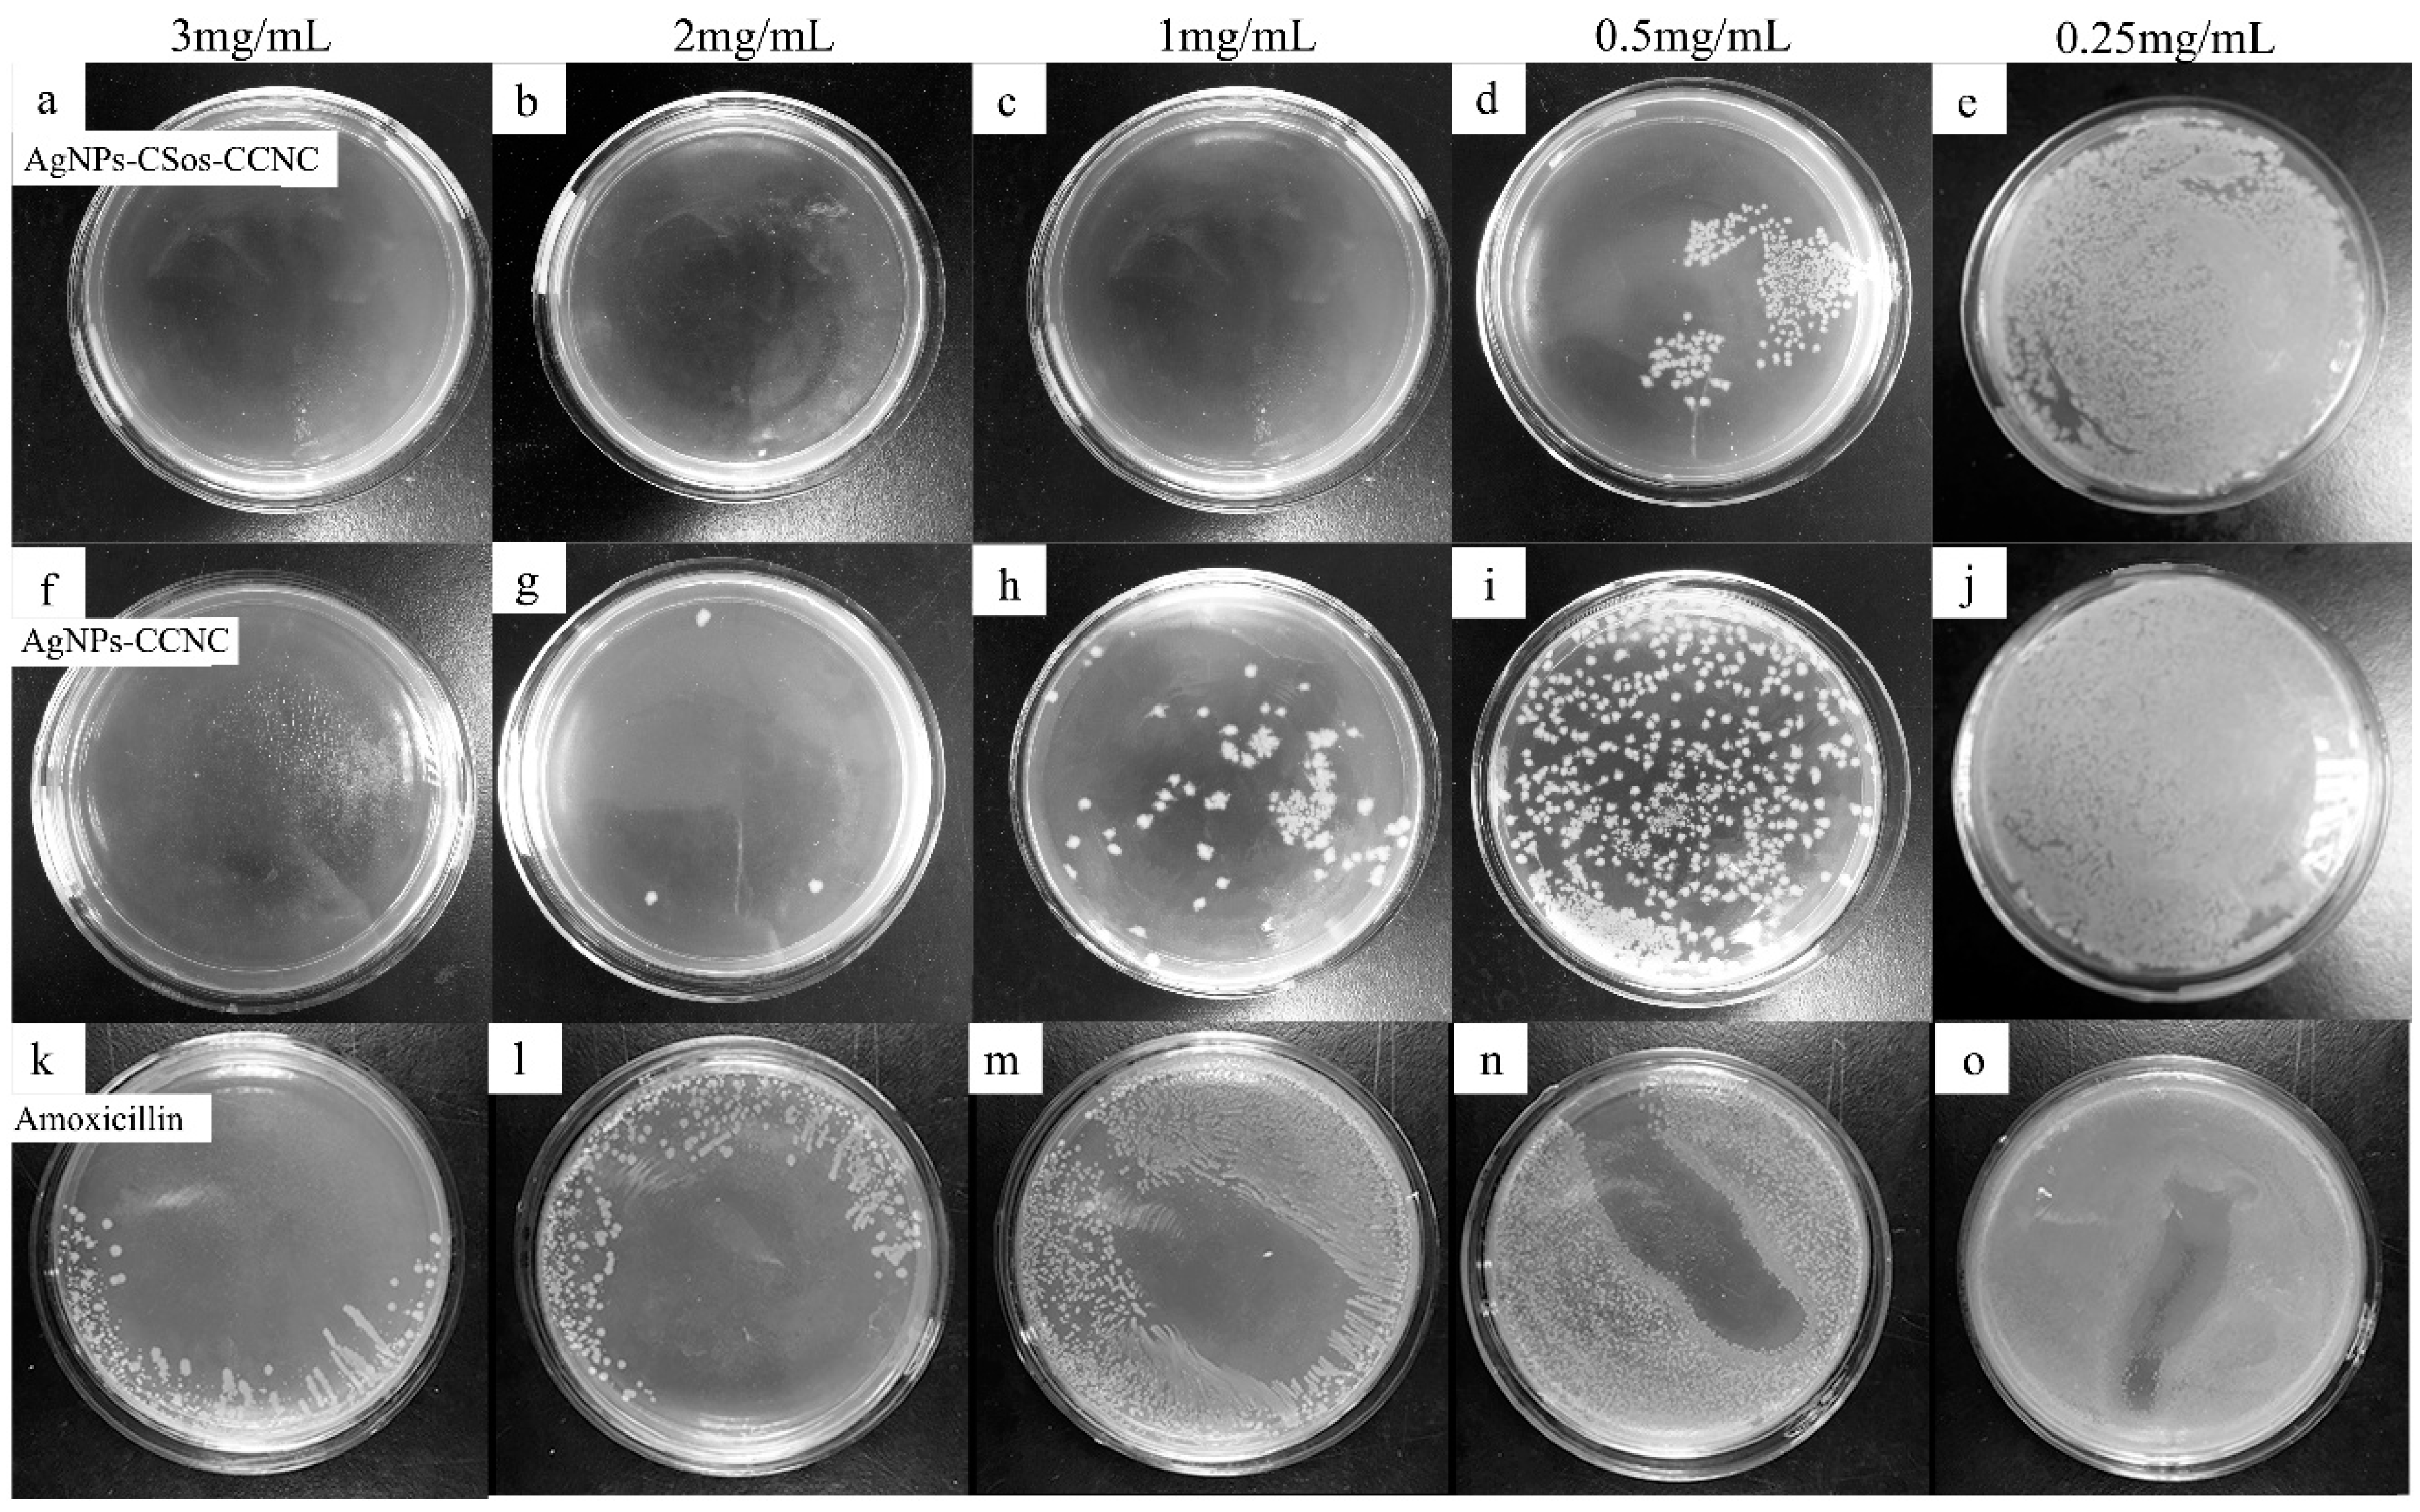
Materials 11 01339 g006 Materials 11 01339 g006

Enhanced Antibacterial Performance and Cytocompatibility of Silver Nanoparticles Stabilized by Cellulose Nanocrystal Grafted with Chito-Oligosaccharides
Abstract
1. Introduction
2. Materials and Methods
2.1. Materials
2.2. Preparation of CCNC
2.3. Preparation of CSos-CCNC
2.4. Preparation of AgNPs Stabilized by Nanoparticles
2.5. Characterization
3. Results and Discussion
3.1. The Morphology and Structure of AgNPs-CCNC
3.2. Characterizations of CCNC and CSos-CCNC
3.3. The Morphology of AgNPs
3.4. Thermal Property of AgNPs-CCNC and AgNPs-CSos-CCNC
3.5. Structural Characteristics of the AgNPs-CCNC and AgNPs-CSos-CCNC
3.6. Antimicrobial Property of AgNPs-CCNC and AgNPs-CSos-CCNC
3.7. Cytotoxicity Evaluation
4. Conclusions
Author Contributions
Funding
Conflicts of Interest
References
- Maneerung, T.; Tokura, S.; Rujiravanit, R. Impregnation of silver nanoparticles into bacterial cellulose for antimicrobial wound dressing. Carbohydr. Polym. 2008, 72, 43–51. [Google Scholar] [CrossRef]
- Rai, M.; Yadav, A.; Gade, A. Silver nanoparticles as a new generation of antimicrobials. Biotechnol. Adv. 2009, 27, 76–83. [Google Scholar] [CrossRef] [PubMed]
- Bulpitt, P.; Aeschlimann, D. New strategy for chemical modification of hyaluronic acid: Preparation of functionalized derivatives and their use in the formation of novel biocompatible hydrogels. J. Biomed. Mater. Res. Part B Appl. Biomater. 1999, 47, 152–169. [Google Scholar] [CrossRef]
- Chen, S.; Liu, K.; Luo, Y.; Jia, D.; Gao, H.; Hu, G.; Liu, L. In situ preparation and sintering of silver nanoparticles for low-cost and highly reliable conductive adhesive. Int. J. Adhes. Adhes. 2013, 45, 138–143. [Google Scholar] [CrossRef]
- Huang, Q.; Wang, J.; Wei, W.; Yan, Q.; Wu, C.; Zhu, X. A facile and green method for synthesis of reduced graphene oxide/Ag hybrids as efficient surface enhanced Raman scattering platforms. J. Hazard. Mater. 2015, 283, 123–130. [Google Scholar] [CrossRef] [PubMed]
- Yuan, S.; Ge, F.; Chen, Y.; Cai, Z. Tunable metal-enhanced fluorescence by pH-responsive polyacryloyl hydrazide capped Ag nanoparticles. RSC Adv. 2017, 7, 6358–6363. [Google Scholar] [CrossRef]
- Shi, Z.; Tang, J.; Chen, L.; Yan, C.; Tanvir, S.; Anderson, W.A.; Berry, R.M.; Tam, K.C. Enhanced Colloidal Stability and Antibacterial Performance of Silver Nanoparticles/Cellulose Nanocrystal Hybrids. J. Mater. Chem. B 2014, 3, 603–611. [Google Scholar] [CrossRef]
- Bordbar, M. Biosynthesis of Ag/almond shell nanocomposite as a cost-effective and efficient catalyst for degradation of 4-nitrophenol and organic dyes. RSC Adv. 2016, 7, 180–189. [Google Scholar] [CrossRef]
- Park, S.; Ko, Y.S.; Jung, H.; Lee, C.; Woo, K.; Ko, G. Disinfection of waterborne viruses using silver nanoparticle-decorated silica hybrid composites in water environments. Sci. Total Environ. 2018, 625, 477–485. [Google Scholar] [CrossRef] [PubMed]
- Lara, H.H.; Garza-Treviño, E.N.; Ixtepan-Turrent, L.; Singh, D.K. Silver nanoparticles are broad-spectrum bactericidal and virucidal compounds. J. Nanobiotechnol. 2011, 9, 1–8. [Google Scholar] [CrossRef] [PubMed]
- Graves, J.L., Jr.; Mehrdad, T.; Quincy, C.; Adero, C.; Herve, N.; Harrison, S.H.; Barrick, J.E. Rapid evolution of silver nanoparticle resistance inEscherichia coli. Front. Genet. 2015, 6, 42. [Google Scholar] [CrossRef] [PubMed]
- Graves, J.L.; Thomas, M.; Ewunkem, J.A. Antimicrobial Nanomaterials: Why Evolution Matters. Nanomaterials 2017, 7, 283. [Google Scholar] [CrossRef] [PubMed]
- Huan, S.; Liu, G.; Han, G.; Bai, L. Electrospun poly(lactic acid)-based fibrous nanocomposite reinforced by cellulose nanocrystals: Impact of fiber uniaxial alignment on microstructure and mechanical properties. Biomacromolecules 2018, 19, 1037. [Google Scholar] [CrossRef] [PubMed]
- Lam, E.; Male, K.B.; Chong, J.H.; Leung, A.C.; Luong, J.H. Applications of functionalized and nanoparticle-modified nanocrystalline cellulose. Trends Biotechnol. 2012, 30, 283. [Google Scholar] [CrossRef] [PubMed]
- Musarrat, J.; Dwivedi, S.; Singh, B.R.; Al-Khedhairy, A.A.; Azam, A.; Naqvi, A. Production of antimicrobial silver nanoparticles in water extracts of the fungus Amylomyces rouxii strain KSU-09. Bioresour. Technol. 2010, 101, 8772–8776. [Google Scholar] [CrossRef] [PubMed]
- Badawy, A.M.E.; Luxton, T.P.; Silva, R.G.; Scheckel, K.G.; Suidan, M.T.; Tolaymat, T.M. Impact of environmental conditions (pH, ionic strength, and electrolyte type) on the surface charge and aggregation of silver nanoparticles suspensions. Environ. Sci. Technol. 2010, 44, 1260–1266. [Google Scholar] [CrossRef] [PubMed]
- Peng, Y.; Song, C.; Yang, C.; Guo, Q.; Yao, M. Low molecular weight chitosan-coated silver nanoparticles are effective for the treatment of MRSA-infected wounds. Int. J. Nanomed. 2017, 12, 295–304. [Google Scholar] [CrossRef] [PubMed]
- Lin, S.; Chen, L.; Huang, L.; Cao, S.; Luo, X.; Liu, K. Novel antimicrobial chitosan–cellulose composite films bioconjugated with silver nanoparticles. Ind. Crops Prod. 2015, 70, 395–403. [Google Scholar] [CrossRef]
- Azzam, F.; Heux, L.; Putaux, J.L.; Jean, B. Preparation by Grafting Onto, Characterization, and Properties of Thermally Responsive Polymer-Decorated Cellulose Nanocrystals. Biomacromolecules 2010, 11, 3652–3659. [Google Scholar] [CrossRef] [PubMed]
- Akhlaghi, S.P.; Berry, R.C.; Tam, K.C. Surface modification of cellulose nanocrystal with chitosan oligosaccharide for drug delivery applications. Cellulose 2013, 20, 1747–1764. [Google Scholar] [CrossRef]
- Cheng, M.; Qin, Z.; Chen, Y.; Liu, J.; Ren, Z. Facile one-step extraction and oxidative carboxylation of cellulose nanocrystals through hydrothermal reaction by using mixed inorganic acids. Cellulose 2017, 24, 3243–3254. [Google Scholar] [CrossRef]
- Cheng, M.; Qin, Z.; Liu, Y.; Qin, Y.; Li, T.; Chen, L.; Zhu, M. Efficient extraction of carboxylated spherical cellulose nanocrystals with narrow distribution through hydrolysis of lyocell fibers by using ammonium persulfate as an oxidant. J. Mater. Chem. A 2013, 2, 251–258. [Google Scholar] [CrossRef]
- Mascheroni, E.; Rampazzo, R.; Ortenzi, M.A.; Piva, G.; Bonetti, S.; Piergiovanni, L. Comparison of cellulose nanocrystals obtained by sulfuric acid hydrolysis and ammonium persulfate, to be used as coating on flexible food-packaging materials. Cellulose 2016, 23, 779–793. [Google Scholar] [CrossRef]
- Yue, Y.; Zhou, C.; French, A.D.; Xia, G.; Han, G.; Wang, Q.; Wu, Q. Comparative properties of cellulose nano-crystals from native and mercerized cotton fibers. Cellulose 2012, 19, 1173–1187. [Google Scholar] [CrossRef]
- Durán, N.; Durán, M.; Jesus, M.B.D.; Seabra, A.B.; Fávaro, W.J.; Nakazato, G. Silver nanoparticles: A new view on mechanistic aspects on antimicrobial activity. Nanomed. Nanotechnol. Biol. Med. 2015, 12, 789–799. [Google Scholar] [CrossRef] [PubMed]
- Rizzello, L.; Pompa, P.P. Nanosilver-based antibacterial drugs and devices: Mechanisms, methodological drawbacks, and guidelines. Chem. Soc. Rev. 2014, 45, 1501–1518. [Google Scholar] [CrossRef] [PubMed]
- Bankura, K.P.; Maity, D.; Mollick, M.M.; Mondal, D.; Bhowmick, B.; Bain, M.K.; Chakraborty, A.; Sarkar, J.; Acharya, K.; Chattopadhyay, D. Synthesis, characterization and antimicrobial activity of dextran stabilized silver nanoparticles in aqueous medium. Carbohydr. Polym. 2012, 89, 1159–1165. [Google Scholar] [CrossRef] [PubMed]

| Code | Tonset (°C) | Tmax (°C) |
|---|---|---|
| AgNPs-CCNC | 212 | 330.18 |
| AgNPs-CSos-CCNC | 199 | 353.41 |
© 2018 by the authors. Licensee MDPI, Basel, Switzerland. This article is an open access article distributed under the terms and conditions of the Creative Commons Attribution (CC BY) license (http://creativecommons.org/licenses/by/4.0/).
Share and Cite
Ni, X.; Wang, J.; Yue, Y.; Cheng, W.; Wang, D.; Han, G. Enhanced Antibacterial Performance and Cytocompatibility of Silver Nanoparticles Stabilized by Cellulose Nanocrystal Grafted with Chito-Oligosaccharides. Materials 2018, 11, 1339. https://doi.org/10.3390/ma11081339
Ni X, Wang J, Yue Y, Cheng W, Wang D, Han G. Enhanced Antibacterial Performance and Cytocompatibility of Silver Nanoparticles Stabilized by Cellulose Nanocrystal Grafted with Chito-Oligosaccharides. Materials. 2018; 11(8):1339. https://doi.org/10.3390/ma11081339
Chicago/Turabian StyleNi, Xiaohui, Jinru Wang, Yiying Yue, Wanli Cheng, Dong Wang, and Guangping Han. 2018. "Enhanced Antibacterial Performance and Cytocompatibility of Silver Nanoparticles Stabilized by Cellulose Nanocrystal Grafted with Chito-Oligosaccharides" Materials 11, no. 8: 1339. https://doi.org/10.3390/ma11081339
APA StyleNi, X., Wang, J., Yue, Y., Cheng, W., Wang, D., & Han, G. (2018). Enhanced Antibacterial Performance and Cytocompatibility of Silver Nanoparticles Stabilized by Cellulose Nanocrystal Grafted with Chito-Oligosaccharides. Materials, 11(8), 1339. https://doi.org/10.3390/ma11081339





